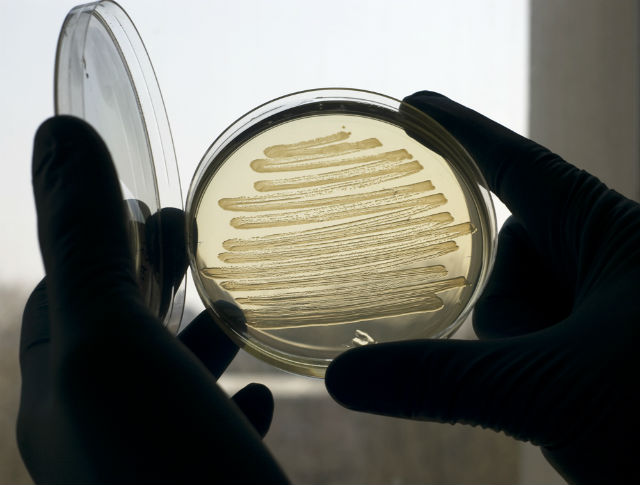

Создав при помощи генной инженерии штамм кишечной палочки (Escherichia coli), учёные заставили бактерию превращать сахар в горючее, которое по составу во многом напоминает обычное дизельное топливо. Если такое процесс поставить на поток, то подобное синтетическое горючее может стать хорошей альтернативой органическому топливу.
Исследование, результаты которого были опубликованы в журнале PNAS, проводил синтетический биолог Джон Лав (John Love) из университета Эксетера.
“Мы хотим сделать так, чтобы производители автомобилей, продавцы топлива и водители даже не заметили разницы между обычным бензином и нашим новым изобретением”, — говорит Лав.
Согласно планам Евросоюза, к 2050 году выбросы парниковых газов необходимо снизить на 80%. Как следствие, к 2020 году хотя бы 10% от общего числа используемого топлива должно будет составлять биотопливо. Однако на сегодняшний день большая часть биодизеля и биоэтанола несовместимы с современными двигателями. Чтобы двигатель функционировал исправно, необходим “коктейль” из 5-10% биотоплива и 90-95% бензина.
Команда Лава создала генно-модифицированную кишечную палочку, которая в отличие от других синтетических аналогов, производит биотопливо, которое можно заливать в бензобак, не смешивая ни с каким другим видом горючего. Плюс такого подхода к созданию биотоплива ещё и в том, что поставщикам топлива не надо будет менять существующую инфраструктуру (доставки и распространения).
Как правило, E. coli поглощают сахар и производят жиры для образования клеточной мембраны. Как сообщается в пресс-релизе, чтобы вместо жиров микроорганизмы производили синтетические молекулы топлива, учёные создали специальный штамм E. coli. В ход пошли технологии синтетической медицины.
Правда, несмотря на своё очевидное преимущество перед конкурентами, новый штамм, возможно, не будет иметь большого успеха у создателей заменителей топлива. Эффективность нового производства пока крайне низкая: сотня литров раствора из бактерий и сахара способна выдать всего одну чайную ложку нового биотоплива.
“Прежде чем мы перейдём к промышленному производству, нам необходимо будет увеличить эффективность работы бактерий. У нас есть в запасе от трёх до пяти лет, чтобы поставить необходимые эксперименты и понять, стоит ли игра свеч”, — рассказывает Лав. Его команда также пытается понять, могут ли кишечные палочки для эффективного производства потреблять вместо сахара животные или человеческие отходы.
Проект финансировали крупный производитель бензина и моторных масел компания Shell и британский Совет исследователей биологии и биотехнологий (BBSRC).
Добавим, что биотопливо считается безопасным для окружающей среды, поскольку производит именно такое количество углекислого газа, которое растения смогут переработать. Но существуют и альтернативные мнения: исследователь окружающей среды Роб Бейли (Rob Bailey) считает, что биотопливо наносит климату Земли даже больший ущерб, чем органические виды топлива, в число которых входит бензин.
Производство биологического топлива нельзя считать панацеей для современной экономики, политики и экологии. Необходимо учитывать, что бактерии, вроде кишечных палочек, также являются природным материалом и, соответственно, могут оказаться в дефиците. Исследователям ещё предстоит решить массу вопросов, связанных с производством топлива из кишечных палочек, прежде чем начать обсуждение практических испытаний и дальнейшей коммерциализации проекта.